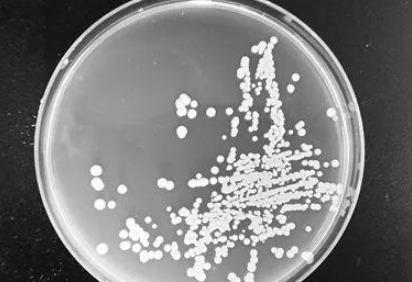

Die California Resources Corporation hat kürzlich das Carbon TerraVault-Kohlenstoffspeicherprojekt in Kern County gestartet, Kaliforniens erstes groß angelegtes Projekt zur Kohlenstoffabscheidung und -speicherung. Das Carbon TerraVault-Projekt fängt Kohlendioxid-Emissionen aus Stromerzeugung und Industrie ein und leitet sie zur dauerhaften Speicherung in unterirdische Gesteinsformationen ein. Damit bietet es Kalifornien einen technischen Weg, seine Klimaneutralitätsziele zu erreichen.

„Für Zement- und Stromproduzenten, die Kohlendioxid in die Atmosphäre ausstoßen, wird CRC Kohlenstoffabscheidungsanlagen installieren, um das Kohlendioxid aufzufangen und sicher in Bohrlöcher zu leiten“, sagte Francisco Leon, Präsident von California Resources. Das Projekt nutzt die bestehende Ölinfrastruktur, um das Kohlendioxid wieder in bestehende Öl- und Gaslagerstätten einzulagern. Chris Gould, Geschäftsführer von Carbon TerraVault, erklärte: „Im Wesentlichen bringen wir den Kohlenstoff dorthin zurück, wo er herkommt. Wir wissen, dass er seit Millionen von Jahren in Kohlenwasserstoffen gebunden ist.“
Das California Air Resources Board hat das Carbon TerraVault-Projekt als strategische Priorität für die Klimaneutralität eingestuft. Steve Cliff, Geschäftsführer des Gremiums, betonte: „Wir arbeiten an der Dekarbonisierung, das heißt an der Reduzierung der Nutzung fossiler Brennstoffe, müssen aber auch den Kohlenstoff entfernen, der die Gesellschaft antreibt.“ Vertreter des Kern County erklärten, das Projekt werde Arbeitsplätze schaffen und gleichzeitig die Emissionsreduzierung fördern.
Als Beginn einer Reihe von Kohlenstoffmanagementprojekten im Central Valley markiert die Umsetzung des Kohlenstoffbindungsprojekts Carbon TerraVault eine neue Etappe in der industriellen Emissionsreduzierung und Energiewende Kaliforniens.